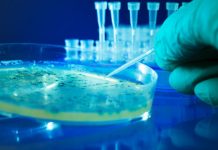
Research: Discovery opens door to preventing the foodborne illness —

Research: Migrating mule deer don’t need directions, study finds —
How do big-game animals know where to migrate across hundreds of miles of vast Wyoming landscapes year after year?
Among scientists, there are two...
Research: Is it autism? The line is getting increasingly blurry —
Around the world, the number of people diagnosed with autism is rising. In the United States, the prevalence of the disorder has grown...
Research: Single change at telomeres controls the ability of cells to generate a complete...
Pluripotent cells can give rise to all cells of the body, a power that researchers are eager to control because it opens the...
Research: Discovery opens door to preventing the foodborne illness —
A pair of University of Virginia School of Medicine scientists have revealed how E. coli seeks out the most oxygen-free crevices of your...
Research: Archaeologists unearth stone tools made 45,000 years ago —
Stone tools uncovered in Mongolia by an international team of archaeologists indicate that modern humans traveled across the Eurasian steppe about 45,000 years...
Research: Some impacts — like sea temperature rise — are already in progress; others...
Sea temperature and ocean acidification have climbed during the last three decades to levels beyond what is expected due to natural variation alone,...
Research: Hurricanes drive the evolution of more aggressive spiders —
Researchers at McMaster University who rush in after storms to study the behaviour of spiders have found that extreme weather events such as...
Research: Iron-60 discovery in the Antarctic provides information on the environment of solar system...
The rare isotope iron-60 is created in massive stellar explosions. Only a very small amount of this isotope reaches Earth from distant stars....
Research: Fluorescent glow may reveal hidden life in the cosmos —
Astronomers have uncovered a new way of searching for life in the cosmos. Harsh ultraviolet radiation flares from red suns, once thought to...
Research: Fracking prompts global spike in atmospheric methane, study suggests —
As methane concentrations increase in the Earth's atmosphere, chemical fingerprints point to a probable source: shale oil and gas, according to new Cornell...
Top News
Hey ISIS, You Suck: Local Muslims Post Anti-ISIS Billboard
A new billboard on Manchester Road in Missouri reads, "HEY ISIS, YOU SUCK!!! From: #ActualMuslims."
A group of Muslim-Americans have put up a blunt billboard...